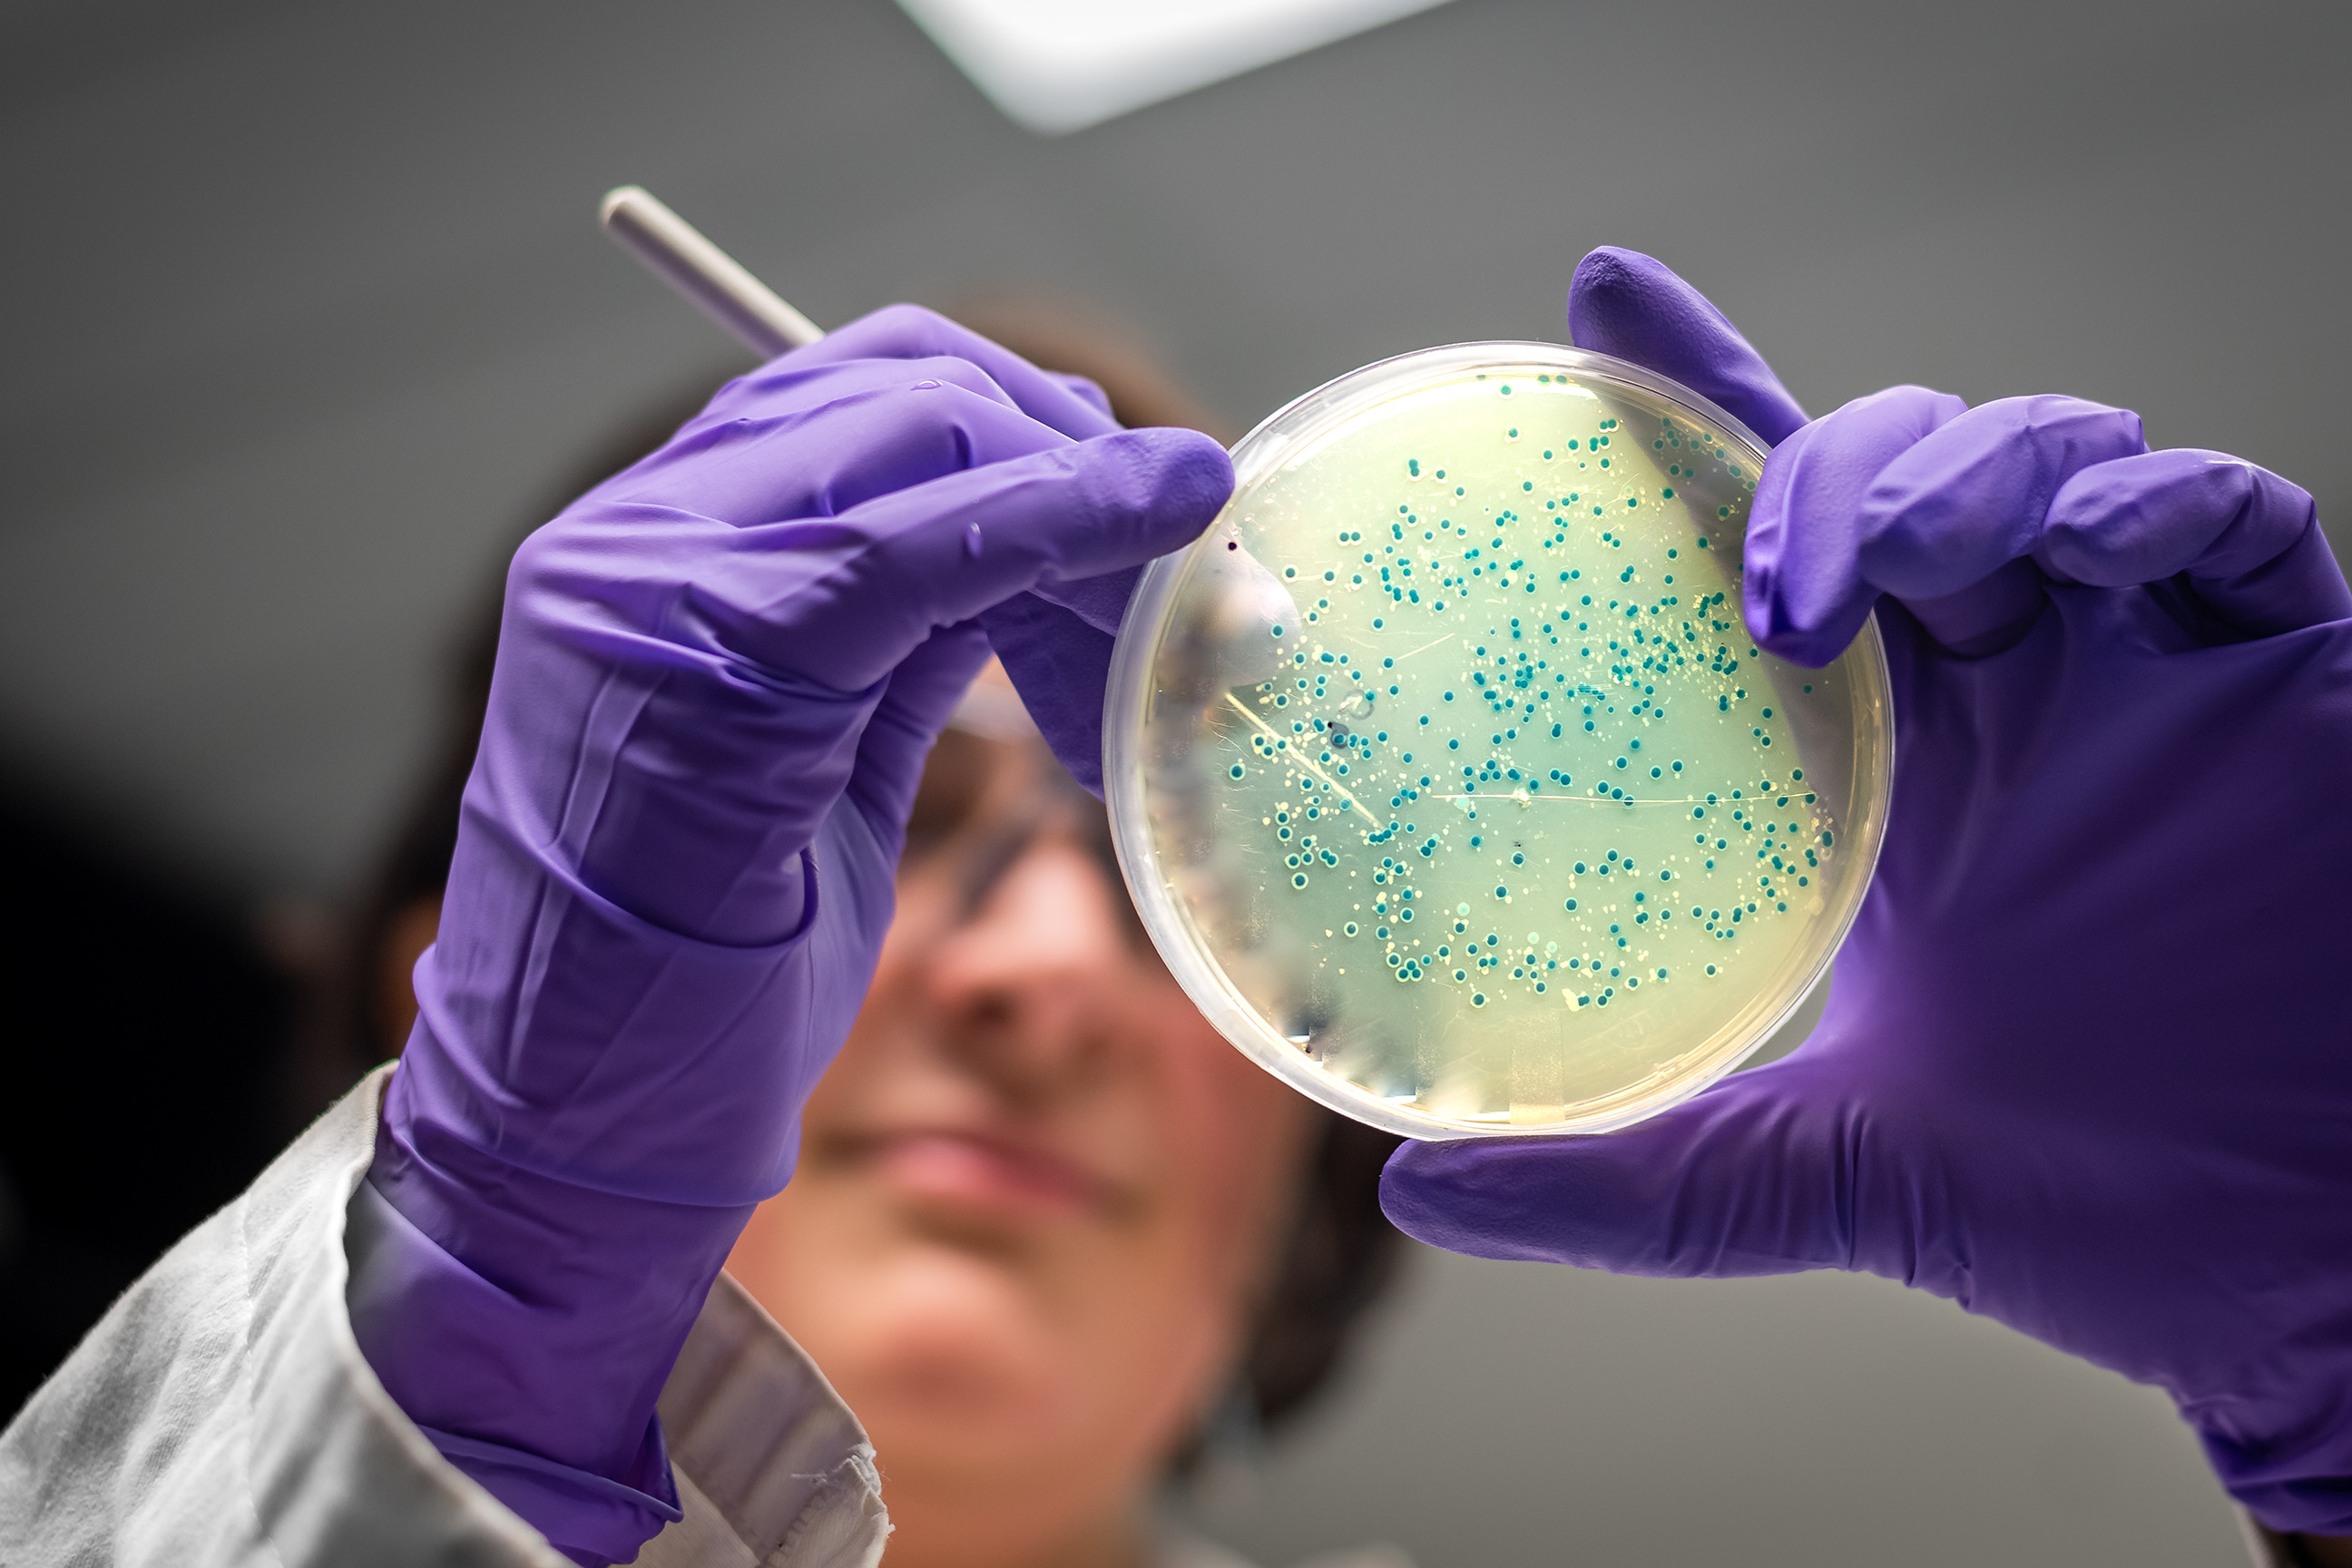
Lab analyst with petri dish

Technika PCR wykrywanie Listeria Monocytogenes w produktach rybnych
25 mar 2021
Zagrożeniem dla czystości mikrobiologicznej końcowej postaci środka spożywczego jakim są ryby (spożywane na surowo lub minimalnie przetworzone) i produkty rybne, może być zanieczyszczony surowiec (jako koszt chociażby braku odpowiedniej higieny procesu obróbki), niewłaściwa higiena procesu produkcyjnego (higiena osobista personelu, czystość powierzchni produkcyjnych urządzeń, woda technologiczna, powietrze, opakowania), ponadto niezachowanie ciągłości łańcucha chłodniczego przechowywania, transportu i dystrybucji.
Nietrwałość mięsa ryb wynika, z:
– wysokiej zawartości wody,
– występowania niebiałkowych związków azotowych, m.in. wolnych aminokwasów (od 15% w mięsie ryb białych do 55% w mięsie ryb spodoustych w przeliczeniu na azot),
– wysokiej aktywności enzymów tkankowych i bakteryjnych już w temperaturze chłodniczej,
– obecności krwi, gdyż po śmierci nie następuje wykrwawienie,
– obecności drobnoustrojów (głównie bakterii) bytujących na powierzchni ryb, a w tuszach niepatroszonych również w przewodzie pokarmowym i skrzelach,
– niewielkiego pośmiertnego spadku wartości pH, niewystarczającej do zahamowania rozwoju patogennej i gnilnej mikroflory.
Na zanieczyszczenie mikrobiologiczne ryb (jako surowca), a w konsekwencji również na trwałość produktu finalnego wpływają dwie grupy czynników: przyżyciowe i pośmiertne.
Czynniki przyżyciowe:
– gatunek ryby,
– genetyczne (np. płeć, w przypadku chowu i hodowli ryb konsumpcyjnych to także przynależność do konkretnej linii hodowlanej, ewentualnie odmiany lokalnej),
– fizjologiczne (wiek, stopień dojrzałości płciowej, ponadto sposób odżywiania, głównie rodzaj pokarmu, stopień wypełnienia przewodu pokarmowego, także aktywność metaboliczna uzależniona od pory roku, kondycja i stan zdrowotny),
– środowiskowe (m.in. mikrobiologiczny stan wody na łowisku),
– rodzaj połowu i związany z nim stopień zmęczenia przedśmiertnego (połowy haczykowe, w przeciwieństwie do przemysłowych dostarczają ryb o lepszej jakości mikrobiologicznej).
Istotny wpływ na zanieczyszczenie i trwałość mikrobiologiczną ryb obok czynników przyżyciowych wywierają czynniki pośmiertne:
– temperatura wody i powietrza podczas połowu,
– mikroflora gnilna pochodząca z wody, kału i śluzu ryb. W śluzie pokrywającym skórę ryb występuje około 102–107 jtk/cm2. Skład jakościowy dominującej mikroflory śluzu zależy przede wszystkim od gatunku ryby, czystości wód, stopnia zasolenia wód i temperatury. Śluz naskórny ma zdolność hamowania rozwoju niepożądanej mikroflory, zawiera m.in. lizozym i inne substancje bakteriostatyczne i bakteriobójcze. Po śmierci śluz, który za życia ryby stanowi warstwę ochronną, zostaje rozłożony, a drobnoustroje obecne na powierzchni przenikają w głąb tkanek mięśniowych podczas przechowywania,
– ewentualna wstępna obróbka ryb po połowie, uszkodzenia skóry (wszelkie uszkodzenia skóry sprzyjają wnikaniu bakterii do mięśni oraz zwiększają ich zanieczyszczenie). Najwięcej bakterii znajduje się w przewodzie pokarmowym ryb, 103–108 jtk/g treści przewodu pokarmowego. Mikroflora przewodu pokarmowego ryb jest jakościowym odbiciem mikroflory bakteryjnej otaczającego środowiska. Ryby niepatroszone często przechowuje się lepiej niż patroszone, co można wytłumaczyć zanieczyszczeniem otwartych mięśni w trakcie patroszenia zarówno mikroflorą z przewodu pokarmowego, jak i z powierzchni ryby, a także drobnoustrojami z narzędzi i rąk pracowników. Wynik patroszenia uzależniony jest w bardzo dużym stopniu od warunków higienicznych wykonywania ww. czynności. Jednak w sytuacji, gdy transport ryb z łowiska na ląd wymaga dłuższego okresu czasu, wówczas zabieg patroszenia wpływa korzystnie na jakość mikrobiologiczną surowca,
– odpowiednie zabezpieczenie ryb bezpośrednio po połowie, w celu ochrony przed zepsuciem. Ryby tuż po złowieniu, jeśli nie zostaną schłodzone lub w inny sposób zakonserwowane staną się niezdatne do spożycia w ciągu kliku, maksymalnie kilkunastu godzin. Powszechnie do chłodzenia ryb używa się lodu, który musi być otrzymany z wody odpowiadającej wymaganiom wody przeznaczonej do spożycia przez ludzi. Przy prawidłowym lodowaniu temperatura tkanki ryb nie powinna być wyższa niż 1oC,
– stan higieniczny statku i sprzętu użytego do połowu (sieci często zanieczyszczone są drobnoustrojami ściekowymi na skutek płukania w wodach przybrzeżnych), a także higieniczne warunki składowania i transportu ryb.
W celu przedłużenia trwałości ryb poddaje się je wielokierunkowym technologiom przerobu (wykorzystując rozmaite metody utrwalania surowca rybnego), uzyskując tym samym szeroki asortyment środków spożywczych – od ryb świeżych (chłodzenie), mrożonych, solonych, wędzonych, suszonych, marynat, wyrobów garmażeryjnych, aż do konserw i prezerw rybnych. Trwałość ryb minimalnie przetworzonych zależy przede wszystkim od temperatury ich przechowywania, im jest ona niższa, tym okres przydatności do spożycia jest dłuższy, czyli najdłuższy w przypadku mrożenia ryb. Ponadto wydłużenie okresu trwałości mikrobiologicznej ryb o małym stopniu przetworzenia umożliwia technologia pakowania próżniowego (VP), zastępowana coraz częściej przez technologię pakowania w modyfikowanej (MAP) i kontrolowanej atmosferze (CA) o optymalnym składzie gazów. Właściwie dobrana mieszanka gazowa w połączeniu z obniżeniem temperatury (chłodnicze przechowywanie) może wydłużyć okres trwałości ryb o kilka kluczowych dni, stanowiąc tym samym bardzo efektywny sposób wydłużania okresu przydatności do spożycia środka spożywczego.
Obecność bakterii chorobotwórczych, m.in. Listeria monocytogenes w rybach i produktach rybnych, sugeruje konieczność stałego monitorowania wszystkich etapów produkcji i dystrybucji, głównie pod względem przestrzegania dobrych praktyk higienicznych.
Listeria monocytogenes
Według obecnie obowiązującej systematyki Bergey’a rodzaj Listeria obejmuje 23 gatunki. Bakterie z rodzaju Listeria to Gram-dodatnie (w starszych hodowlach spotyka się także komórki Gram-ujemne), nieprzetrwalnikujące, krótkie pałeczki z tendencją do polimorfizmu. Występują pojedynczo lub w parach, mogą układać się także w krótkie łańcuszki (3–5 komórek bakteryjnych). Pałeczki z rodzaju Listeria są urzęsione perytrychalnie i nie wytwarzają otoczek.
Bakterie z rodzaju Listeria są w naturze wszechobecne. Występują powszechnie w glebie, wodzie, osadach morskich, a nawet ściekach. Z uwagi na powszechność występowania Listeria sp. bardzo ważne jest, aby już na etapie surowca i dalszego przetwarzania żywności przeprowadzać szczegółowe kontrole, które ograniczą ryzyko zanieczyszczenia produktu finalnego. Nie jest to jednak proste zadanie, ponieważ pałeczki z rodzaju Listeria są bakteriami doskonale adaptującymi się do niekorzystnych warunków środowiska.

Pałeczki Listeria monocytogenes są etiologicznym czynnikiem listeriozy. Listerioza jest zoonozą. Do zakażenia może dojść podczas bezpośredniego kontaktu z zainfekowanymi wydzielinami/wydalinami chorego zwierzęcia, np. podczas jego pielęgnacji, a także po spożyciu zakażonych surowych, wędzonych ryb i innych produktów wtórnie zanieczyszczonych podczas cyklu produkcyjnego, począwszy od pozyskiwania surowca, warunków przetwarzania, po transport i magazynowanie do dystrybucji finalnego środka spożywczego. To właśnie nieodpowiednio przetworzona i przechowywana żywność stanowi główne źródło zakażenia chorobotwórczymi szczepami Listeria sp. Również ludzie zdrowi mogą być bezobjawowymi nosicielami Listeria monocytogenes (bakterie występują głównie w pochwie i przewodzie pokarmowym, rzadziej w układzie oddechowym). Szacuje się, że około 5–10% populacji ludzi jest nosicielami tego gatunku.
Wirulentne właściwości Listeria monocytogenes umożliwiają jej pokonanie trzech barier obronnych organizmu: błony śluzowej jelit, bariery naczyń krwionośnych w mózgu (bariera krew-mózg) oraz bariery łożyskowej.
Dawka infekcyjna chorobotwórczych szczepów Listeria sp. nie jest dobrze poznana i różni się w zależności od szczepu, a także od wrażliwości osobniczej gospodarza. Z danych epidemiologicznych wynika, że chorobotwórcze szczepy bakterii z gatunku Listeria monocytogenes należą do serotypów: 1/2a, 1/2b, 4b. Listerioza u człowieka może przybierać postać: nieinwazyjną (przebieg łagodny, nierzadko bezobjawowy o samoograniczającym się charakterze) i inwazyjną (przebieg ostry). Listerioza inwazyjna jest związana z populacjami immunologicznie wrażliwymi, do których należą: kobiety w ciąży, płody, noworodki, niemowlęta, osoby w podeszłym wieku, osoby z obniżoną odpornością. Dawka infekcyjna dla tych osób mieści się w przedziale 102 do 103 żywych komórek. Z chorób odzwierzęcych, właśnie listerioza stanowi najwyższy odsetek hospitalizowanych przypadków (97%), z najwyższym współczynnikiem śmiertelności (20–30%).
Podsumowując, kliniczna infekcja Listeria monocytogenes zależy od trzech głównych czynników:
- liczby bakterii przyjętych m.in. z żywnością,
- patogennych właściwości szczepu związanych z rodzajem serotypu,
- immunologicznego statusu chorego.
Gwarancją bezpieczeństwa i jakości żywności jest przestrzeganie prawa żywnościowego na wszystkich etapach produkcji – od uzyskania surowców, od uzyskania surowców, poprzez przetwarzanie, dystrybucję, do momentu dostarczenia jej do konsumenta.

Obecność bakterii chorobotwórczych, m.in. Listeria monocytogenes w rybach i produktach rybnych, sugeruje konieczność stałego monitorowania wszystkich etapów produkcji i dystrybucji, głównie pod względem przestrzegania dobrych praktyk higienicznych.

Częstotliwość badania powierzchni produkcyjnych na obecność patogenu Listeria monocytogenes zależy od kilku czynników:
– rodzaju wytwarzanego środka spożywczego (surowy, minimalnie przetworzony, RTE, wysoko przetworzony, poziom aktywności wody, pH i in.), istotą jest również stopień przetworzenia surowca,
– możliwości zanieczyszczenia krzyżowego,
– podczas procesu mycia i dezynfekcji należy zwrócić szczególną uwagę na trudno dostępne miejsca w środowisku produkcji (nisze ekologiczne do wzrostu Listeria monocytogenes). Pałeczki z rodzaju Listeria mogą trwale bytować: w szczelinach/ mikropęknięciach, w których zawsze gromadzi się wilgoć (istotą jest jakość i kondycja powierzchni), na pojemnikach używanych do przechowywania żywności oczekującej na dalsze przetwarzanie lub pakowanie, w kratkach ściekowych, wyłącznikach, na kółkach wózków i podnośników widłowych, również w ewentualnych zastoinach wody, na powierzchniach gumowych (bardzo ważny jest rodzaj materiału, z którego wykonana jest instalacja technologiczna), w niedokładnie wyrównanych miejscach połączeń spawanych i in., i zanieczyszczać środowisko produkcji,
– częstotliwości prowadzenia zabiegów mycia i dezynfekcji pomieszczeń i wyposażenia.
Wyeliminowanie potencjalnych dróg mikrobiologicznego zanieczyszczenia, dzięki zachowaniu aseptycznych warunków produkcji w zakładzie, prawidłowej higieny personelu, a także przestrzeganiu procedur bezpieczeństwa, umożliwia otrzymanie bezpiecznego produktu, który nie zagraża zdrowiu, czy życiu konsumenta.
Łańcuchowa Reakcja Polimerazy (Polymerase Chain Reaction)
Część technologii przetwarzania wykorzystywanych w przetwórstwie ryb umożliwia powstanie środków spożywczych o krótkich terminach przydatności do spożycia, m.in.: filety z ryb świeżych, ryby wędzone na gorąco, wyroby garmażeryjne i in. W tej sytuacji czas ma ogromne znaczenie i tu z pomocą przychodzą metody biologii molekularnej. Większość metod molekularnych bazuje na technice PCR (ang. Polymerase Chain Reaction). Łańcuchowa reakcja polimerazy jest skutecznym narzędziem wykrywania, identyfikacji i różnicowania pałeczek Listeria monocytogenes.
Klasyczna analiza mikrobiologiczna (PN-EN ISO 11290-2) choć uznana za niezawodną i skuteczną, wymaga kilku dni (min. 4 dni – do uzyskania wyniku ujemnego), a czasem i kilkunastu do momentu uzyskania ostatecznego rezultatu. Zdarza się, że fenotypowe cechy stanowiące kryterium identyfikacji nie ulegają ekspresji, co uniemożliwia prawidłową diagnozę. Innym problemem są tzw. formy VBNC (ang. Viable But NonCulturable) („żywe, lecz nie dające się hodować”). Konwencjonalne metody hodowlane (płytkowe) pozwalają na oznaczenie zaledwie 1–10% składu populacji stanowiącej określony ekosystem. Znaczna część mikroorganizmów aktywna metabolicznie, jest niezdolna do wzrostu w postaci kolonii na pożywkach agarowych. Przejście komórek od pełnej aktywności fizjologicznej do stanu VBNC zachodzi głównie w stresogennych warunkach środowiska (np. jako skutek procesu dezynfekcji w zakładzie produkcji). Komórki drobnoustrojów chorobotwórczych w fazie VBNC pozostają metabolicznie aktywne. Osiąganie przez szczepy patogenne stadium VBNC stanowi poważny problem zdrowotny, zwłaszcza, że komórki te cechuje większa wirulencja w porównaniu do komórek o pełnej aktywności fizjologicznej. Zastosowanie metod analitycznych (np. PCR) pozwalających precyzyjnie wykryć bakterie w stanie VBNC przyczynia się do znacznej poprawy kontroli bezpieczeństwa zdrowotnego żywności.
Metoda opiera się na powieleniu (amplifikacji) specyficznego dla danego gatunku fragmentu DNA in vitro. Warunkiem przeprowadzenia reakcji PCR jest znajomość sekwencji krótkiego fragmentu DNA na końcach 5’ i 3’, który może być powielony.
Do przeprowadzenia reakcji PCR są potrzebne:
– matryca – dwuniciowa cząstka DNA, której fragment chcemy powielić,
– startery (primery) – krótkie, jednoniciowe fragmenty DNA o długości około 10–20 nukleotydów i sekwencji komplementarnej do matrycowego DNA,
– substraty reakcji w postaci mieszaniny 4 nukleotydów (A – adenina, G – guanina, C – cytozyna, T – tymina), czyli dNTP,
– enzym katalizujący reakcję. Termostabilna polimeraza DNA, która na bazie jednoniciowego DNA, będącego matrycą, syntetyzuje nić komplementarną. Najczęściej używa się polimerazy z Thermus aquaticus, tzw. Taq polimeraza,
– reagenty pomocnicze, takie jak np. jony Mg2+.
PCR jest reakcją cykliczną (etapy tworzą cykle, które są wielokrotnie powtarzane). Każdy cykl zwykle składa się z trzech etapów (kolejne etapy reakcji PCR wyznaczane są przez zmianę temperatury):
- Denaturacja matrycowego DNA. Wysoka temperatura (około 95oC) powoduje zerwanie wiązań wodorowych pomiędzy komplementarnymi zasadami podwójnej helisy (dsDNA) (ang. double-stranded DNA), produktem są dwie cząsteczki jednoniciowe (ssDNA) (ang. single-stranded DNA).
- Hybrydyzacja starterów (przyłączanie primerów – ang. annealing) (często tj. 45–65oC). Do jednoniciowych cząsteczek matrycowego DNA przyłączane są startery.
- Wydłużenie łańcucha (elongacja). Temperatura tego etapu cyklu zależy od właściwości polimerazy. Dla polimerazy Taq optymalną jest temperatura 72o
Polimeraza dobudowuje kolejne nukleotydy do starterów – następuje synteza nici komplementarnych do nici matrycowej. Kierunek syntezy: 5’→ 3’.
Cykl powtarza się około 40 razy w zależności od ilości materiału, który chce się uzyskać. Dodatkowo wyróżnia się dwa etapy, które następują po wykonaniu odpowiedniej ilości cykli:
- Końcowe wydłużanie (temperatura działania polimerazy). Jego celem jest naprawienie ewentualnych pomyłek, które powstały przy syntezie komplementarnych nici DNA oraz renaturację wszystkich cząstek ssDNA do matrycowego DNA.
- Schładzanie, które zapobiega degradacji produktów PCR.
Teoretycznie ilość produktu po każdym cyklu amplifikacji powinna rosnąć wykładniczo (po n cyklach z jednej cząsteczki DNA powstaje jej 2n kopii), jednak w wyniku wyczerpania się składników reakcji spada aktywność polimerazy, tym samym obniża się wydajność amplifikacji. W klasycznym PCR analiza ilości powielonego produktu prowadzona jest dopiero po zakończeniu wszystkich cykli reakcji, czyli w fazie plateau. Z kolei zastosowanie real-time PCR pozwala na monitorowanie ilości amplifikowanego DNA po każdym cyklu reakcji przy użyciu barwników fluorescencyjnych. Intensywność sygnału fluorescencyjnego jest proporcjonalna do ilości produktu reakcji.
Należy jednak pamiętać, że techniką PCR jest wykrywane także DNA z martwych komórek bakteryjnych, które nie stanowią zagrożenia dla zdrowia publicznego. Jednak ten problem również można rozwiązać, uwzględniając rozcieńczenie próbki związane z etapem jej przednamnażania (wzbogacenie hodowli w żywe komórki docelowego patogenu, tj. 106–107 jtk/ml hodowli, przy jednoczesnym zmniejszeniu ilości komórek martwych). Etap izolacji DNA to kolejne rozcieńczenia, a do samej reakcji PCR wykorzystujemy mikroobjętości lizatu, co skutkuje dalszym rozcieńczeniem próbki wyjściowej. Całkowite rozcieńczenie próbki wyjściowej wynosi zatem kilka tysięcy razy.
Komplikacją poprawnej detekcji patogenów w żywności i środowisku jej produkcji mogą być inhibitory reakcji PCR znajdujące się w matrycach żywnościowych oraz w środkach myjących i dezynfekujących. Problem ten rozwiązano poprzez dodawanie do reakcji PCR wewnętrznej kontroli amplifikacji IAC (ang. Internal Amplification Control). IAC PCR dopuszcza niezależną amplifikację w tej samej mieszaninie reakcyjnej docelowej sekwencji DNA i kontroli wewnętrznej przy wykorzystaniu tego samego zestawu starterów. Nadrzędną zaletą IAC PCR jest zwiększenie czułości reakcji PCR. Jednocześnie wewnętrzna kontrola amplifikacji zapobiega pojawianiu się wyników fałszywie ujemnych, związanych z obecnością inhibitorów reakcji PCR.
PCR pozwala uniknąć błędów diagnostycznych, co zasadniczo zwiększa bezpieczeństwo potencjalnego konsumenta eliminując wyniki fałszywie ujemne (omówione powyżej), tudzież zabezpiecza producentów żywności przed wynikami fałszywie dodatnimi, które potrafią naruszyć renomę przedsiębiorstwa i narazić je na ogromne koszty.
W podsumowaniu czas oczekiwania na wynik badania mikrobiologicznego, szczególnie istotny dla producenta żywności. Po etapie izolacji DNA, amplifikacja oraz detekcja zachodzą w termocyklerze w ciągu kilkudziesięciu minut. Całkowity czas wykonania oznaczenia razem z etapem przednamnażania to około 24 godziny (w przypadku wyniku ujemnego). Konieczne jest jednak potwierdzenie wyniku z etapu detekcji (w przypadku wyniku dodatniego). Ponadto PCR umożliwia wykrywanie specyficznej sekwencji DNA patogenów w żywności z wysoką selektywnością i specyficznością.
Literatura:
- Jadhav S., Bhave M., Palombo E.A., Methods used for the detection and subtyping of Listeria monocytogenes, Journal of Microbiological Methods, 2012, 88 (3): 327-341
- Kołożyn – Krajewska D. Higiena produkcji żywności Wydawnictwo SGGW 2013
- Lachtara B., Wieczorek K., Osek J., Molekularne metody wykrywania Listeria monocytogenes w żywności, Medycyna Weterynaryjna, 2016, 72(1): 12-17
- Libudzisz Z, Kowal K., Żakowska Z. Mikrobiologia techniczna tom 2, Wydawnictwo Naukowe PWN 2008
- Litwińczuk Z. Towaroznawstwo surowców i produktów zwierzęcych Powszechne Wydawnictwo Rolnicze i Leśne 2012
- Marciniak M., Robak M., PCR jako narzędzie do identyfikacji i różnicowania drobnoustrojów, Acta Scientiarum Polonorum, Biotechnologia, 2012, 11 (2): 5-16
- Molenda J. Mikrobiologia żywności pochodzenia zwierzęcego Wydawnictwo Uniwersytetu przyrodniczego we Wrocławiu 2010
- Peters I.R., Helps C.R., Hall E.J. Day M.J. Real-time RT-PCR: considerations for efficient and sensitive assay design. Journal of Immunological Methods, 2004, 286: 203-217
- Rozporządzenie Komisji (WE) nr 2073/2005 z dnia 15 listopada 2005 r. w sprawie kryteriów mikrobiologicznych dotyczących środków spożywczych
- Sikorski Z.E. Ryby i bezkręgowce morskie pozyskiwanie, właściwości i przetwarzanie Wydawnictwo Naukowo – Techniczne 2004
- Sołtysiuk M.M., Szteyn J., Wiszniewska-Łaszczych A., Bakterie z rodzaju Listeria zagrożeniem dla zdrowia ludzi i zwierząt, Medycyna Weterynaryjna, 2019, 75 (4): 214-220
- Ward C.L., Dempsey M.H., Ring C.J.A., Kempson R.E., Zhang L., Gor D., Snowden B.W., Tisdale M. Design and performance testing of quantitative real time PCR assays for influenza A and B viral load measurement. Journal of Clinical Virology, 2004, 29: 179–188
- www.cict.bacterio.fr [dostęp: 12-01-2021]
Skorzystaj z naszych usług, aby mieć pewność, że dostarczasz żywność bezpieczną, niezagrażającą zdrowiu i życiu konsumenta.
Telefon: +48 24 235 71 81
E-mail: laboratorium.polska@intertek.com